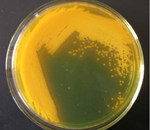

更多>>中心简介

西北农林科技大学动物科学虚拟仿真实验教学中心,其历史可追溯至建校之初的1936年,有76年的建设发展史。1999年组建了“动物科学实验教学中心”。依托畜牧兽医两个一级学科,15个二级博(硕)士学科点,支撑8个相关本科专业的实验实践教学、科研创新与技术服务功能。
2007年11月获批国际级动物科学实验教学示范中心(建设单位)后,学校高度重视并大力支持,先后投入专项资金累计6903万元。中心按照“分社、统管、共享、开放”的建设与管理原则,设立了7个功能实验室46个分实验室,5个共享开放的学科科研创新平台,7大校内实践教学平台,并在杨凌区内14家企业建立了校外实践教学基地。
更多>>中心动态